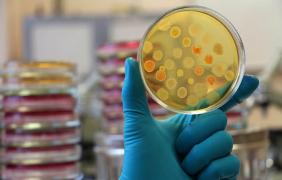
VIRUSUL BREXIT face ravagii în Marea Britanie: Autorităţile sunt în ALERTĂ! Mii de persoane sunt infectate

VEŞTI BUNE pentru ROMÂNII din Marea Britanie! Ce drepturi vor primi aceştia, după Brexit
VEŞTI BUNE pentru ROMÂNII din Marea Britanie! Ce drepturi vor primi aceştia, după BrexitVeşti bune pentru români stabiliţi în Marea Britanie! Premierul Theresa May a confirmat că europenii care au trăit în ultimii...
pe 23.06.2017 la 16:47
Negocierile pentru Brexit au început cu o victorie pentru românii care trăiesc de cel puţin cinci ani în Marea Britanie
Negocierile pentru Brexit au început cu o victorie pentru românii care trăiesc de cel puţin cinci ani în Marea BritaniePremierul Theresa May a confirmat că europenii care au trăit în ultimii cinci ani în REGAT, vor primi drepturi egale cu cele...
pe 23.06.2017 la 13:13
VEŞTI BUNE pentru românii din Marea Britanie! Ce se va întâmpla cu cetăţenii UE după Brexit. ANUNŢUL făcut de Theresa May
VEŞTI BUNE pentru românii din Marea Britanie! Ce se va întâmpla cu cetăţenii UE după Brexit. ANUNŢUL făcut de Theresa MayPremierul Theresa May a anunţat, joi, în cursul summitului european de la Bruxelles, care sunt planurile Marii Britanii în ceea...
pe 22.06.2017 la 23:53
Ambasadorul Marii Britanii la Bucureşti, mesaj pentru ROMÂNI! Ce urmează după Brexit
Ambasadorul Marii Britanii la Bucureşti, mesaj pentru ROMÂNI! Ce urmează după BrexitRomânii care trăiesc şi lucrează şi studiază în Marea Britanie sunt bine-veniţi în continuare, în pofida Brexit, a dat...
pe 22.06.2017 la 21:14
Securitatea în UE şi Brexit-ul, temele summitului Consiliului European de la Bruxelles
Securitatea în UE şi Brexit-ul, temele summitului Consiliului European de la BruxellesLiderii UE participă joi la un summit concentrat pe Brexit şi pe securitate, la Bruxelles, la scurt timp după un atentat terorist...
pe 22.06.2017 la 14:25
CONTROVERSĂ! Pălăria purtată de Regina Marii Britanii la ceremonia discursului din Parlament a declanşat un val de reacţii pe Internet (FOTO, VIDEO)
CONTROVERSĂ! Pălăria purtată de Regina Marii Britanii la ceremonia discursului din Parlament a declanşat un val de reacţii pe Internet (FOTO, VIDEO)Regina Marii Britanii a purtat la ceremonia de deschidere a sesiunii Parlamentului o pălărie care semăna foarte mult cu steagul...
pe 21.06.2017 la 20:48
UE "nu va face concesii" Marii Britanii în privinţa Brexit: " Fiecare parte să îşi asume responsabilitatea şi consecinţele pentru deciziile sale"
UE "nu va face concesii" Marii Britanii în privinţa Brexit: " Fiecare parte să îşi asume responsabilitatea şi consecinţele pentru deciziile sale"Şeful echipei de negociere a UE, Michel Barnier, a declarat, după prima rundă de negociere cu Londra, că nu intenţionează să...
pe 20.06.2017 la 09:24Preşedintele Iohannis şi omologul său german, discuţii pe Brexit şi relaţia transatlantică din NATO
Preşedintele Iohannis şi omologul său german, discuţii pe Brexit şi relaţia transatlantică din NATOPreşedintele Klaus Iohannis a fost primit, luni, de către omologul său german Frank-Walter Steinmeier cu care a discutat, printre...
pe 19.06.2017 la 22:02
PRIMA ZI a negocierilor pentru BREXIT! La ce ACORD au ajuns UE şi Marea Britanie privind drepturile imigranţilor, inclusiv ale românilor
PRIMA ZI a negocierilor pentru BREXIT! La ce ACORD au ajuns UE şi Marea Britanie privind drepturile imigranţilor, inclusiv ale românilorUniunea Europeană şi Regatul Unit au ajuns, luni, la un acord asupra priorităţilor şi calendarului negocierilor asupra...
pe 19.06.2017 la 21:56
BREXIT, ziua divorțului: încep negocierile pentru ieșirea Marii Britanii din Uniunea Europeană
BREXIT, ziua divorțului: încep negocierile pentru ieșirea Marii Britanii din Uniunea EuropeanăTheresa May intră luni în negocierile dificile de divorţ de Uniunea Europeană, care vor decide viitorul şi influenţa Marii...
pe 19.06.2017 la 11:37
Marea Britanie şi UE încep NEGOCIERILE pentru Brexit
Marea Britanie şi UE încep NEGOCIERILE pentru BrexitNegocierile dintre Uniunea Europeană şi Marea Britanie privind Brexit-ul sunt programate să înceapă luni la Bruxelles, chiar...
pe 19.06.2017 la 08:36
BREXIT, răsturnare MAJORĂ de situaţie! Germania face un ANUNŢ SURPRIZĂ (VIDEO)
BREXIT, răsturnare MAJORĂ de situaţie! Germania face un ANUNŢ SURPRIZĂ (VIDEO)Într-un interviu acordat Bloomberg, ministrul german al Finanțelor, Wolfgang Schaeuble, a declarat că Uniuniunea Europeană...
pe 14.06.2017 la 08:27
Regina i-a dat Theresei May mandat pentru a forma un nou guvern! Discuţiile pentru Brexit vor începe peste 10 zile
Regina i-a dat Theresei May mandat pentru a forma un nou guvern! Discuţiile pentru Brexit vor începe peste 10 zilePremierul conservator britanic Theresa May a primit vineri din partea Reginei Elisabeta a II-a mandatul de a forma un nou guvern în...
pe 09.06.2017 la 15:00
Britanicii îşi aleg un nou Parlament, după Brexit. Aproximativ 47 de milioane de oameni sunt aşteptaţi la urne
Britanicii îşi aleg un nou Parlament, după Brexit. Aproximativ 47 de milioane de oameni sunt aşteptaţi la urneDupă săptămâni de teroare şi trei atacuri teroriste, britanicii îşi aleg un nou Parlament. 47 de milioane de oameni sunt...
pe 08.06.2017 la 19:57
VIRUSUL BREXIT face ravagii în Marea Britanie: Autorităţile sunt în ALERTĂ! Mii de persoane sunt infectate
VIRUSUL BREXIT face ravagii în Marea Britanie: Autorităţile sunt în ALERTĂ! Mii de persoane sunt infectateZeci de mii de persoane sunt infectate cu o boală potenţial mortală ca urmare a consumului de carne importată din Europa,...
pe 22.05.2017 la 11:11
SONDAJ. După ieşirea din Uniunea Eropeană, britanicii ar părăsi şi EUROVISIONUL!
SONDAJ. După ieşirea din Uniunea Eropeană, britanicii ar părăsi şi EUROVISIONUL!După ce au votat anul trecut pentru ieșirea din Uniunea Europeană, britanicii sunt acum gata să părăsească și concursul...
pe 13.05.2017 la 11:22
Agenţia Europeană a Medicamentului s-ar putea muta în România, după relocarea din Marea Britanie
Agenţia Europeană a Medicamentului s-ar putea muta în România, după relocarea din Marea BritaniePreşedintele Camerei Deputaţilor, Liviu Dragnea, a declarat marţi că îi va cere oficial şefului Comisiei Europene, Jean-Claude...
pe 09.05.2017 la 19:01
Germania cere TAXĂ Marii Britanii pentru accesul pe piața unică a UE, după BREXIT
Germania cere TAXĂ Marii Britanii pentru accesul pe piața unică a UE, după BREXITOficiali din Guvernul german au propus acordarea de acces pe piaţa unică a UE pentru Marea Britanie, în schimbul unei taxe,...
pe 06.05.2017 la 15:59
ANUNŢ de ultimă oră privind DREPTURILE ROMÂNILOR care locuiesc în Marea Britanie, după BREXIT. Declaraţii OFICIALE
ANUNŢ de ultimă oră privind DREPTURILE ROMÂNILOR care locuiesc în Marea Britanie, după BREXIT. Declaraţii OFICIALEMinistrul Brexitului, David Davis, a declarat, miercuri, că negociatorii britanici vor să obţină un acord generos de ieşire...
pe 03.05.2017 la 17:45
Ministrul britanic pentru Brexit: " Nu vom plăti 100 de miliarde de euro", în schimbul ieşirii din UE
Ministrul britanic pentru Brexit: " Nu vom plăti 100 de miliarde de euro", în schimbul ieşirii din UEMarea Britanie nu va achita o "notă de plată" de 100 de miliarde de euro în schimbul ieşirii sale din Uniunea Europeană, a dat...
pe 03.05.2017 la 10:44
Recep Tayyip Erdogan: "Turcia va alege următoarea cale a unui fel de Brexit prin referendum"
Recep Tayyip Erdogan: "Turcia va alege următoarea cale a unui fel de Brexit prin referendum"Preşedintele turc Recep Tayyip Erdogan spune că Turcia va decide prin referendum dacă îşi va continua drumul către aderarea la...
pe 02.05.2017 la 11:31
După Brexit, vine Frexit? Emmanuel Macron, candidatul proeuropean la preşedinţia Franţei, lansează ipoteza
După Brexit, vine Frexit? Emmanuel Macron, candidatul proeuropean la preşedinţia Franţei, lansează ipotezaPrezidenţiabilul En Marche, Emmanuel Macron, a declarat luni dimineaţă că blocul comunitar trebuie să se reformeze ori se va...
pe 01.05.2017 la 09:55
Premierul Theresa May atrage atenţia asupra "notei de plată" a britanicilor pentru Brexit
Premierul Theresa May atrage atenţia asupra "notei de plată" a britanicilor pentru BrexitPremierul Marii Britanii, Theresa May, a avertizat duminică după-amiază că vor exista momente extrem de dificile în negocierea...
pe 30.04.2017 la 13:23
Preşedintele Klaus Iohannis a vorbit despre românii din Marea Britanie şi ce se întâmplă cu ei după Brexit
Preşedintele Klaus Iohannis a vorbit despre românii din Marea Britanie şi ce se întâmplă cu ei după BrexitPreședintele Klaus Iohannis a vorbit, sâmbătă, la summitul de la Bruxelles, despre românii din Marea Britanie și situația...
pe 29.04.2017 la 17:37
BREAKING NEWS: Liderii europeni AU APROBAT principiile directoare pentru negocierea Brexitului, la summitul de la Bruxelles
BREAKING NEWS: Liderii europeni AU APROBAT principiile directoare pentru negocierea Brexitului, la summitul de la BruxellesPreşedintele Consiliului European, Donald Tusk, a anunţat că liderii europeni au aprobat în mod unanim, în cadrul summitului...
pe 29.04.2017 la 14:43
Preşedintele Iohannis discută soarta românilor din Marea Britanie, la Consiliul European
Preşedintele Iohannis discută soarta românilor din Marea Britanie, la Consiliul EuropeanPreşedintele Klaus Iohannis a declarat, sâmbătă, înaintea începerii lucrărilor Consiliului European de la Bruxelles, că...
pe 29.04.2017 la 14:16
Preşedintele Iohannis participă la Consiliul European dedicat Brexit-ului
Preşedintele Iohannis participă la Consiliul European dedicat Brexit-uluiPreşedintele Klaus Iohannis participă sâmbătă la reuniunea Consilului European, în format 27, pe tema Brexit-ului, urmând să...
pe 29.04.2017 la 07:17
EFECTUL BREXIT. Declaraţie jignitoare la adresa românilor din Marea Britanie: "Nu avem nevoie de oameni de genul celor care culeg fructe”
EFECTUL BREXIT. Declaraţie jignitoare la adresa românilor din Marea Britanie: "Nu avem nevoie de oameni de genul celor care culeg fructe”Lordul Nigel Lawson, un membru marcant al Partidului Conservator şi fost ministru britanic al Finanţelor, a declarat, vineri, în...
pe 28.04.2017 la 23:10
Premierul britanic spune că declaraţiile lui Merkel privind Brexit arată că negocierile se anunţă dure
Premierul britanic spune că declaraţiile lui Merkel privind Brexit arată că negocierile se anunţă durePremierul britanic Theresa May a subliniat joi că declaraţiile cancelarului german Angela Merkel în privinţa Brexit, precum şi...
pe 27.04.2017 la 21:51
PLAN DE URGENȚĂ pentru românii din Marea Britanie, după BREXIT!
PLAN DE URGENȚĂ pentru românii din Marea Britanie, după BREXIT!În urmă cu câteva zile, preşedintele Comisiei Europene, Jean-Claude Juncker, anunţa că "adevăratele" negocieri pentru Brexit,...
pe 22.04.2017 la 11:04
PLANUL SECRET al Marii Britanii, după BREXIT! Jurnaliştii The Sunday Times au pus mâna pe DOCUMENTE STRATEGICE
PLANUL SECRET al Marii Britanii, după BREXIT! Jurnaliştii The Sunday Times au pus mâna pe DOCUMENTE STRATEGICEDezvăluiri importante făcute de publicaţia The Sunday Times! Mai multe documente aparţinând unui înalt funcţionar public...
pe 10.04.2017 la 11:38
Negocieri la Bruxelles, pentru BREXIT. Situaţia românilor din Marea Britanie, tranşată azi în Parlamentul European
Negocieri la Bruxelles, pentru BREXIT. Situaţia românilor din Marea Britanie, tranşată azi în Parlamentul EuropeanParlamentul European a adoptat, astăzi, cu o largă majoritate, prioritățile sale în negocierile privind ieșirea Marii Britanii...
pe 05.04.2017 la 14:36
ANUNŢ SURPRIZĂ făcut de analişti: Ce ţară din Europa VA PIERDE cel mai mult din cauza Brexit
ANUNŢ SURPRIZĂ făcut de analişti: Ce ţară din Europa VA PIERDE cel mai mult din cauza BrexitMarea Britanie a declanşat, săptămâna trecută, procedura de ieşire din Uniunea Europeană, iar analiştii s-au grăbit să...
pe 04.04.2017 la 11:26
Muncitorii străini FUG din Marea Britanie. Alex, român stabilit la Londra: “Nu vreau ca băieţelul meu să fie HĂRŢUIT la grădiniţă. Nu mai spun că sunt român" (FOTO)
Muncitorii străini FUG din Marea Britanie. Alex, român stabilit la Londra: “Nu vreau ca băieţelul meu să fie HĂRŢUIT la grădiniţă. Nu mai spun că sunt român" (FOTO)Marea Britanie a declanşat procedura de ieşire din Uniunea Europeană, iar străinii care au sperat la o viaţă mai bună atunci...
pe 03.04.2017 la 12:03
EFECTUL BREXIT. Un fost ministru de Externe dezvăluie ce categorie de ROMÂNI va fi cea mai afectată (VIDEO)
EFECTUL BREXIT. Un fost ministru de Externe dezvăluie ce categorie de ROMÂNI va fi cea mai afectată (VIDEO)Odată cu ieşirea iminentă a Marii Britanii din Uniunea Europeană, în Regat se iau decizii care afectează milioane de oameni.
pe 02.04.2017 la 14:47
DETALIUL NEŞTIUT al Brexitului! Cerere FĂRĂ PRECEDENT înaintată la Bruxelles de negociatorul Comisiei Europene (VIDEO)
DETALIUL NEŞTIUT al Brexitului! Cerere FĂRĂ PRECEDENT înaintată la Bruxelles de negociatorul Comisiei Europene (VIDEO)Negociatorul Comisiei Europene pentru Brexit, Michel Barnier, vrea ca oficialii britanici şi europeni să lucreze în franceză în...
pe 01.04.2017 la 13:20
UDMR, decizie de ULTIMĂ ORĂ! Cum vor MAGHIARII să profite de pe urma BREXIT
UDMR, decizie de ULTIMĂ ORĂ! Cum vor MAGHIARII să profite de pe urma BREXIT"Dacă dorim ca o Europă puternică să fie un adevărat cămin pentru minoritățile autohtone - căminul maghiarilor din România...
pe 01.04.2017 la 11:03
Avertisment clar pentru britanici, după ce s-a declanţat Brexit-ul
Avertisment clar pentru britanici, după ce s-a declanţat Brexit-ulLa două zile de la declanşarea Brexitului, Preşedintele Consiliului European a prezentat, ieri, o abordare a negocierilor pentru...
pe 01.04.2017 la 08:42
Frankfurt, noua destinaţie a imigranţiilor din Londra, după BREXIT
Frankfurt, noua destinaţie a imigranţiilor din Londra, după BREXITFrankfurt nu este Paris şi Frankfurt nu este Londra. Frankfurt este Frankfurt. Asta este declaraţia unui specialist în...
pe 31.03.2017 la 13:40
UE către Marea Britanie: "Mai întâi negociem divorţul, apoi acordurile comerciale"
UE către Marea Britanie: "Mai întâi negociem divorţul, apoi acordurile comerciale"Theresa May vrea ca procesul să se desfăşoare mai repede şi să poată negocia în paralel acordul care va reglementa...
pe 31.03.2017 la 08:33
Detaliul neştiut al Brexitului: Theresa May a trimis la Bruxelles DOUĂ SCRISORI. Ce conţinea scrisoarea secretă? (FOTO)
Detaliul neştiut al Brexitului: Theresa May a trimis la Bruxelles DOUĂ SCRISORI. Ce conţinea scrisoarea secretă? (FOTO)Miercuri, 29 martie 2017, a fost o zi istorică, după ce Marea Britanie a declanşat procedura de ieşire a ţării din Uniunea...
pe 30.03.2017 la 18:54
Brexit, motiv de petrecere în Londra
Brexit, motiv de petrecere în LondraBrexitul a fost motiv de petrecere, dar şi de proteste, la Londra! S-au bucurat conservatorii, care s-au străduit din răsputeri...
pe 30.03.2017 la 16:42
Ce pretenţii are Casa Albă de la Regatul Unit după BREXIT?
Ce pretenţii are Casa Albă de la Regatul Unit după BREXIT?Casa Albă şi-a exprimat miercuri dorinţa ca Regatul Unit să rămână un ”leader” în Europa şi în lume, după ce Londra a...
pe 29.03.2017 la 21:35
Brexit, un nou început și pentru românii care muncesc în Marea Britanie
Brexit, un nou început și pentru românii care muncesc în Marea BritanieÎn capitala Marii Britanii, viaţa curge în continuare în ritmul obişnuit. Londonezii încă nu ştiu cât de mult vor fi...
pe 29.03.2017 la 19:30
Prințul Charles a ajuns la București în ziua declanșării Brexit-ului!
Prințul Charles a ajuns la București în ziua declanșării Brexit-ului!În ziua declanşării Brexit-ului, moştenitorul Coroanei britanice începe un turneu european la Bucureşti. Prinţul Charles va...
pe 29.03.2017 la 19:21
Ce spune scrisoarea prin care Marea Britanie se desparte de Uniunea Europeană şi ce a cerut Theresa May liderilor continentali
Ce spune scrisoarea prin care Marea Britanie se desparte de Uniunea Europeană şi ce a cerut Theresa May liderilor continentaliAmbasadorul Marii Britanii la UE, Sir Tim Barrow, i-a înmânat astăzi preşedintelui Consiliului European, Donald Tusk, scrisoarea...
pe 29.03.2017 la 16:29
Consiliul European REGRETĂ ieşirea Marii Britanii din UE, dar a dat asigurări că...
Consiliul European REGRETĂ ieşirea Marii Britanii din UE, dar a dat asigurări că...Consiliul European şi-a exprimat miercuri „regretul că Marea Britanie va ieşi din Uniunea Europeană”, dar a dat asigurări...
pe 29.03.2017 la 15:54
Sorin Grindeanu: "Pentru România, Regatul Unit este un partener ESENŢIAL şi aşa va rămâne"
Sorin Grindeanu: "Pentru România, Regatul Unit este un partener ESENŢIAL şi aşa va rămâne"Premierul Sorin Grindeanu îşi exprimă regretul că Marea Britanie nu va mai fi un partener în cadrul comunităţii europene,...
pe 29.03.2017 la 15:40
S-a dat STARTUL oficial la Brexit! Preşedintele CE a primit scrisoarea în care este invocat Articolul 50. May: Nu mai există cale de întoarcere (LIVE VIDEO)
S-a dat STARTUL oficial la Brexit! Preşedintele CE a primit scrisoarea în care este invocat Articolul 50. May: Nu mai există cale de întoarcere (LIVE VIDEO)Ambasadorul Marii Britanii la UE, Sir Tim Barrow, i-a înmânat astăzi preşedintelui Consiliului European, Donald Tusk, scrisoarea...
pe 29.03.2017 la 15:00
Ziua declanşării BREXIT! Ei sunt cei care vor NEGOCIA ieşirea Marii Britanii din Uniunea Europeană (GALERIE FOTO)
Ziua declanşării BREXIT! Ei sunt cei care vor NEGOCIA ieşirea Marii Britanii din Uniunea Europeană (GALERIE FOTO)Astăzi, ambasadorul britanic pe lângă UE, Tim Barrow, va înmâna personal președintelui Consiliului European, Donald Tusk,...
pe 29.03.2017 la 11:49

